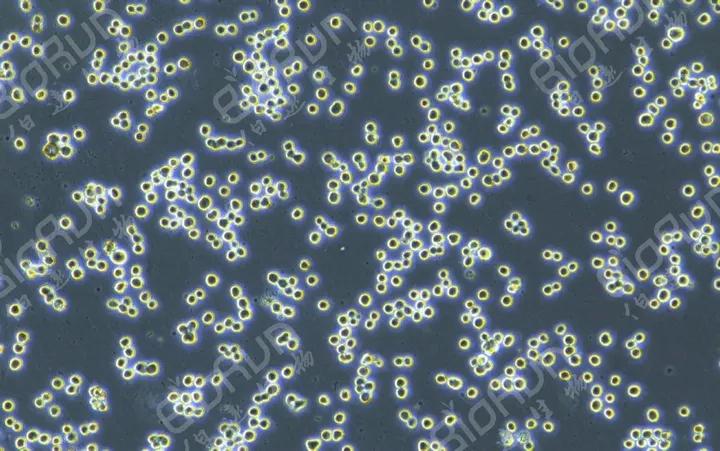
昆虫细胞培养基检测,昆虫饲养手册怎么写
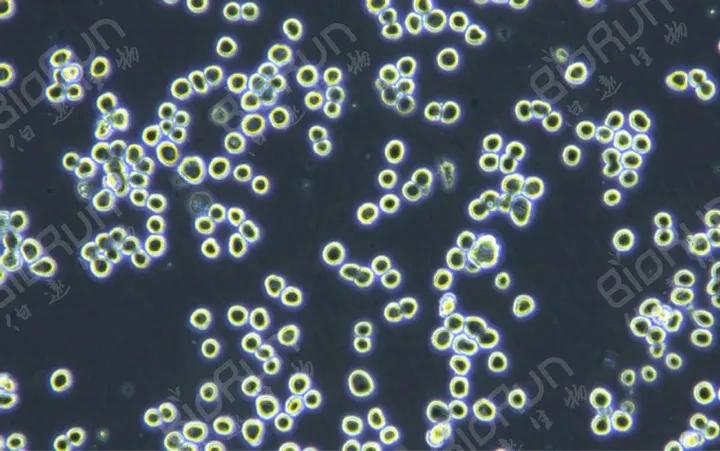
昆虫细胞培养基检测,昆虫饲养手册怎么写

之前小医在【干货】细胞培养的良心操作!一文里介绍了有关细胞培养的一些知识,细胞培养作为很多实验的基础,在生物工程领域的重要性不言而喻。现在,随着昆虫杆状病毒表达载体系统(BEVS)的广泛应用,昆虫细胞的体外培养也越来越受到重视。从1915年,昆虫细胞培养起始,经过一百多年的发展,已在细胞、分子、医学等方向广泛应用。目前,常用于培养的昆虫细胞以草地贪夜蛾细胞株Sf9和Sf21,以及粉纹夜蛾细胞株Tn5B1-4(商品名High Five)为主。
下面以Sf9为例,具体讲解一下昆虫细胞培养的要点

▲Sf9细胞正常生长状态图
细胞基本信息
Sf9昆虫细胞系来自雌性草地贪夜蛾卵巢组织,是利用杆状病毒表达系统进行重组蛋白表达的合适宿主。虽然以往人们利用由培养瓶和含血清基础培养基组成的静止培养系统进行昆虫细胞的培养,但是一般而言昆虫细胞并无贴壁依赖性,更适于进行悬浮培养。

细胞特性
(1)细胞静置培养时半贴壁生长,也可以使用摇瓶悬浮培养;
静置培养时细胞会大量附着瓶底生长,呈半贴壁状态,会有少部分细胞悬浮生长;摇瓶培养时可以很快适应悬浮生长,呈单个或小聚团悬浮生长。
(2)对温度极为敏感;
细胞需尽量控制在26~28℃培养,以保证细胞生长状态;若温度低于26℃,细胞生长速度会变慢,但恢复温度后生长速度会逐渐恢复,不会对细胞产生过大伤害;若温度28℃~30℃,细胞生长严重受限;若温度高于30℃,细胞将受到不可逆伤害,即使温度恢复也无法恢复正常生长状态;同时注意使用的培养基、PBS及其他试剂应保持室温(最好26~28℃),另外尽量减少观察细胞次数和时间。
(3)细胞可以适应多种培养体系。
该细胞多用于真核细胞蛋白表达系统,因此针对该细胞有诸多培养体系,例如Grace's Insect Medium、SF900 II、TNM-FH、ESF921等培养体系,包括含血清的培养体系和不含血清的培养体系,可以根据自身实验需要选择逐步更换为合适的培养体系。
昆虫细胞培养注意事项
昆虫细胞传代/冻存/复苏的一般步骤与哺乳动物细胞相同,(想了解细胞传代/冻存/复苏的操作步骤,可以去看【干货】细胞培养的良心操作!)但有些关键点又有所不同。
(1)昆虫细胞应于28°C、非湿化环境中培养。培养昆虫细胞时建议不要进行CO2交换,所以培养瓶选择密闭盖;
(2)使用昆虫细胞专用的培养基;
(3)贴壁昆虫细胞:细胞密度低于汇合状态的20%时,细胞生长会受到抑制。健康状态最好的细胞是对数期收获的细胞,故昆虫细胞应在对数期传代。但是,如果培养的是强贴壁性昆虫细胞,则应在细胞达到汇合状态或者刚刚开始从培养瓶底部脱离时进行传代,因为此时细胞容易脱离;
(4)某些昆虫细胞系可能需要一定的过程来适应悬浮培养。进行细胞悬浮培养时无需更换培养基。定期传代时需要吸出细胞悬液,然后加入适量培养基,将细胞稀释到适当的密度。添加新鲜培养基后可使细胞营养素达到完全补充;
(5)贴壁昆虫细胞在无血清培养条件下,昆虫细胞与基质贴附极为牢固,需要花费较大力气才能使其脱落。要使细胞脱落,最佳的方法是盖紧瓶盖,并以瓶盖朝上的方向抓住培养瓶,在台面上以中等力量敲击瓶底2~3次,这样将会有足够的细胞解离下来用于传代。
注意
千万不要剧烈摇晃培养瓶,昆虫细胞对吹打、气泡等机械损伤非常敏感,若吹打力度过大、气泡过多将严重影响细胞生长状态,甚至造成细胞损伤。
知识拓展
了解了常规昆虫细胞的培养方法之后,我们再来看一个特殊的昆虫细胞培养——褐飞虱原代细胞培养。
褐飞虱属于半翅目昆虫,是水稻的主要害虫之一。许益鹏等人通过建立一种褐飞虱细胞的培养方法,为科研人员在离体条件下研究褐飞虱及其防治提供了重要帮助。
该方法具体步骤如下:
(1)获取发育时间在3~4天的褐飞虱胚胎:褐飞虱雌雄成虫配对后放入装有水稻叶鞘的试管中,使它们在28℃条件下产卵。在第二天的同一时间从叶鞘中剥出褐飞虱产的卵,定义为1天卵,依次获得褐飞虱的3天卵和4天卵。在解剖镜下,3天卵可看到明显的黄斑,4天卵可观察到眼点,此3天或4天卵的发育时期处于反转期前后,适合后续的胚胎细胞培养;
(2)褐飞虱细胞培养基的配制:分别称取12.25g的Schneider’s insect medium、5.35g的Medium 199、25mL的1×Medum CMRL 1066、2.36g的L-His HCL H2O、2.135g的L-His、149mL~248mL胎牛血清、0.30g的CaCl2、0.20g的NaHCO3、62mg的氨苄青霉素钠、62mg的硫酸链霉素,上述各成分混合,加入超纯水至1000mL使上述成分充分溶解,再用2M NaOH或HCL溶液调节pH至6.5~6.6,而后用超纯水定容至1240mL,经0.22μm微孔滤膜过滤后置于4℃备用,过滤过程采用无菌操作;
(3)机械法结合消化法分离褐飞虱胚胎的组织和细胞:取100粒褐飞虱3天或4天卵,用75%的酒精表面消毒5~10分钟,接着用无菌PBS漂洗3遍,而后把卵转移到培养皿中,加入100μL的无菌PBS,用无菌弯尖眼科剪把卵剪碎,使卵中胚胎组织裸露到PBS中。用无菌枪头把含有胚胎组织的PBS吸到无菌离心管中,800~1000转/分钟离心5~10分钟,去除上部PBS,获得胚胎组织沉淀。用100μL 0.0025g/mL的胰蛋白酶溶液(含或不含EDTA)悬浮胚胎组织,37℃下消化1~5分钟,往胰蛋白酶溶液中加入一倍体积以上的步骤(2)配置的褐飞虱细胞培养基终止胰蛋白酶消化,800~1000转/分钟,离心5~10分钟,去除上清液,获得消化后的胚胎组织和细胞沉淀。整个过程采用无菌操作;
(4)褐飞虱胚胎细胞的原代培养:用褐飞虱细胞培养基1200μL悬浮上述褐飞虱胚胎组织和细胞沉淀,将其转移到小细胞培养皿或6孔细胞培养板中,用封口膜包好后放置于27℃恒温培养箱中培养。第2天,待组织和细胞贴壁后,更换新鲜褐飞虱细胞培养基,并视贴壁细胞生长情况,每隔5~8天更换一次培养基。1个月后,即可以得到贴壁生长的褐飞虱细胞群。整个过程采用无菌操作。
声明:本文知识拓展内容来源于许益鹏等人的发明专利,知识版权属于原作者所有,如有侵权,请联系我们及时删除。
参考文献
许益鹏,俞晓平,申屠旭萍等.一种褐飞虱细胞的原代培养方法[P].浙江省:CN103667173B,2015-08-19.